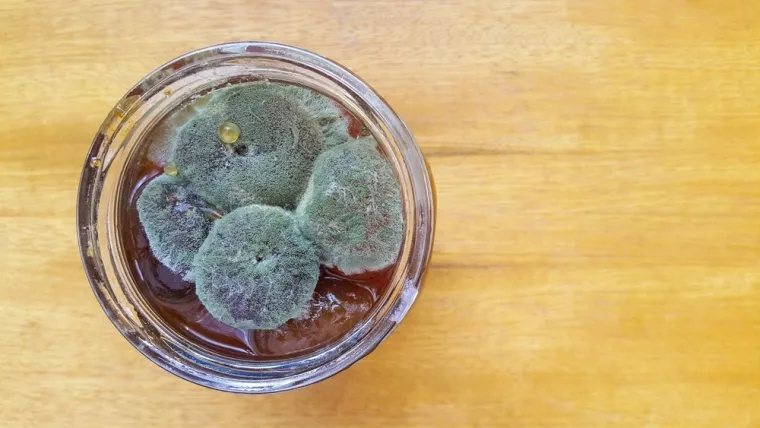
Pojavila vam se plijesan u staklenci džema? Budite oprezni, opasnije je nego &scaron;to mislite

Pojavila vam se plijesan u staklenci džema? Budite oprezni, opasnije je nego što mislite

Pravilno postupanje može spriječiti zdravstvene rizike i omogućiti sigurno zbrinjavanje ostataka
Jedan od najčešćih problema pri čuvanju domaćih džemova je pojava plijesni. Iako je vidljivi sloj plijesni odmah očigledan, mnogi ne shvaćaju da plijesan u džemu može biti puno opasnija nego što se čini na prvi pogled.
Premda je sadržaj staklenke već nepovratno uništen, mnogi zaboravljaju da sama staklenka još uvijek može biti koristan resurs, piše Foodie Score.
Opasnosti koje se skrivaju u pljesnivom džemu
Iako je primamljivo samo odstraniti vidljivi sloj plijesni i nastaviti koristiti džem, stručnjaci s Prehrambeno-biotehnološkog fakulteta u Zagrebu upozoravaju da to može biti opasno. Naime, pod površinom plijesni razvija se mreža korjenastih niti, tzv. micelij, koji prodire kroz cijeli sadržaj staklenke.
Osim toga, određene vrste plijesni mogu stvarati mikotoksine - otrovne tvari koje ne možete vidjeti, okusiti ni pomirisati, a mogu biti prisutne u cijelom džemu, ne samo u dijelu prekrivenom plijesni. Konzumacija mikotoksina može izazvati brojne zdravstvene probleme, od probavnih smetnji do ozbiljnijih dugoročnih posljedica kao što su oštećenje jetre, bubrega ili povećani rizik od karcinoma.
Bacite džem, sačuvajte staklenku
S obzirom na nevidljivu prijetnju, jedino sigurno rješenje jest baciti cijeli sadržaj staklenke u kojoj se pojavila plijesan. Nemojte riskirati svoje zdravlje pokušavajući spasiti nekoliko žlica džema.
Ipak, staklenu teglu i poklopac nikako nemojte bacati. Staklo je materijal koji se može višekratno koristiti bez gubitka kvalitete. Nakon što ste bacili džem, staklenku i poklopac temeljito operite vrućom vodom i deterdžentom. Nakon toga, ključno ih je pravilno sterilizirati kako biste uništili sve zaostale spore plijesni i bakterije. Time osiguravate da su spremni za sigurnu pripremu iduće ture zimnice.
Prevencija je najbolje rješenje
Kako biste izbjegli buduća razočaranja, usredotočite se na prevenciju. Tri su ključna koraka za džem bez plijesni.
- Besprijekorna sterilizacija: Prije punjenja, staklenke i poklopce obavezno sterilizirajte. Najpouzdanija metoda je kuhanje u kipućoj vodi najmanje 10 minuta. Ovo je korak koji se ne smije preskočiti.
- Hermetičko zatvaranje: Pravilno zatvorena staklenka stvara vakuum koji sprječava ulazak zraka i mikroorganizama. Nakon što se džem ohladi, provjerite je li poklopac uvučen. Ako se prilikom pritiska čuje "klik", staklenka nije dobro zatvorena i takav džem treba prvi potrošiti te čuvati u hladnjaku.
- Pravilno skladištenje: Neotvorene staklenke čuvajte na hladnom, tamnom i suhom mjestu, poput smočnice. Izbjegavajte blizinu izvora topline ili direktnu sunčevu svjetlost jer promjene temperature mogu oslabiti vakuumski čep. Nakon otvaranja, džem uvijek držite u hladnjaku.
POGLEDAJTE GALERIJU
POGLEDAJTE VIDEO: DHMZ objavio analizu: Evo gdje je ovo ljeto bilo najtoplije